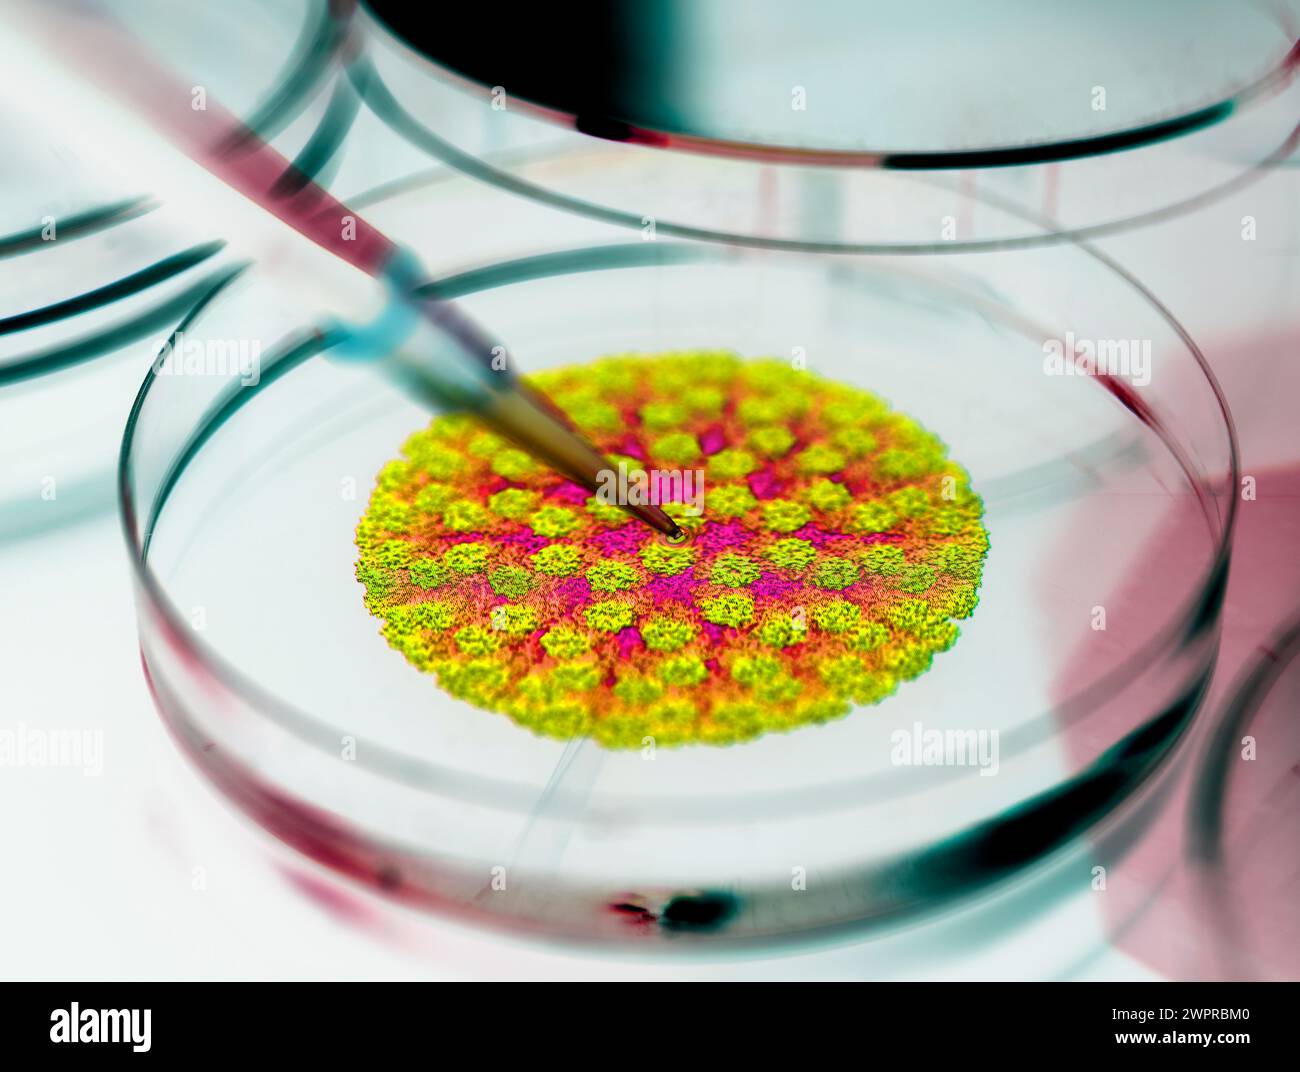
Ricerca di bug di stomaco, immagine concettuale. Scienziato pipettando un campione in una piastra di Petri con un modello molecolare di una particella di rotavirus nel backgroun Foto Stock

Dati complessi Immagini Stock
(30,330)Filtri rapidi:
Dati complessi Immagini Stock

RF2PJM978–Tecnologia dei big data e scienza dei dati. Analista di dati che analizza e visualizza set di dati complessi su schermo virtuale. Informatica, genomica, int. Artificiale

RF2MB4JD6–Foglio di calcolo di dati complesso con frecce verdi e rosse come simbolo di una prospettiva economica e commerciale molto incerta

RF2J6E940–Rete neurale di dati complessi di grandi dimensioni, concetto di visualizzazione dei dati informativi, analisi aziendale, background tecnologico

RFTYCT7X–Vettore grande astratto per la visualizzazione di dati. Complesso thread di dati grafico. Abstract la grafica vettoriale. Infografico futuristico illustrazione

RFM3EA9N–Nodo, punti e linee. Particelle di astratta geometrica sfondo grafico. Struttura di atomi, molecole e comunicazione. Grande complesso di dati con composti.

RF2B6DBAG–Infografica futuristica. Informazioni design estetico. Visualizzazione grafica di thread di dati complessi. Grafico dati astratti

RFM2HBEC–Visualizzazione complesse dei dati e della tecnologia di lavorare insieme. 3D illustrazione
RF2E0405W–Icone di modelli rotondi di logo infografiche per la visualizzazione dei dati, settore di serie vettoriali per la visualizzazione di informazioni complesse

RF2PRRRYN–Visualizzazione concettuale dei big data. Parola per gli insiemi che così complesso che il software tradizionale non può occuparsi di loro

RM2PPHECK–Didascalia concettuale Big Data. Parola per gli insiemi che così complesso che il software tradizionale non può occuparsi di loro

RFFAB91G–Complesso di antenna di ricezione di dati di telemetria circa lo stato del sistema, che è ottenuto in remoto

RF3BF6GAY–Dati sulla borsa sullo sfondo del paesaggio urbano moderno. Interfaccia virtuale di online trading platform. Digital indici economici e finanziari complessi analyti

RFH8CMMJ–Grande complesso di dati. Grafica di sfondo astratto di comunicazione. Sfondo in prospettiva di profondità. Array minimo con composti di linee e di punti. Digital per la visualizzazione di dati. Illustrazione vettoriale di dati di grandi dimensioni.

RF3DBKA34–Sfondo astratto con tecnologia digitale monocromatica con linee di circuito e nodi bianchi su sfondi scuri. Rete dati complessa, intelligenza artificiale, artifici

RF2B7YW0G–Contesto vettoriale del sistema scientifico e tecnologico per il calcolo di dati complessi.

RF3D2CPMH–L'INTELLIGENZA ARTIFICIALE elabora reti di dati complesse e alimenta la trasformazione digitale, consentendo l'automazione, la generazione di informazioni strategiche e soluzioni aziendali innovative

RF2R79J7P–Scienza dei dati e tecnologia dei big data. Gli scienziati dei dati elaborano, analizzano e visualizzano flussi di dati complessi sul computer. Data mining, int. Artificiale

RF2MB4JDE–Foglio di calcolo di dati complesso con frecce rosse come simbolo di una prospettiva di business negativa e di una crisi economica

RF2J6X7BC–Rete neurale di dati complessi di grandi dimensioni, concetto di visualizzazione dei dati informativi, analisi aziendale, background tecnologico, monitor in prospettiva

RFW0WX2X–Vettore grande astratto per la visualizzazione di dati. Complesso thread di dati grafico. Abstract la grafica vettoriale. Infografico futuristico illustrazione

RFM17J2A–Atomo di astratto o griglia molecolare. Digitali complessi schiera di maglie di nodi. Punto geometrico e la linea dello sfondo. Web globale dei dati. Illustrazione Vettoriale

RF2B3BDAM–Infografica futuristica. Informazioni design estetico. Visualizzazione grafica di thread di dati complessi. Grafico dati astratti

RMD1T05G–Un centro dati complesso in cui Amazon.com è noto di locazione dello spazio in ASHBURN, Virginia.

RF2E03TER–Impostare elementi infografici rotondi, petali di fiori vettoriali segmenti di un modello di cerchio per la visualizzazione di dati di informazioni complesse

RF3B838E7–Health Data Privacy come argomento complesso, legato a importanti argomenti che si diffondono come Word cloud.

RF2PYFE92–Scrittura a mano di testo Big Data. Parola per gli insiemi che così complesso che il software tradizionale non può occuparsi di loro

RM2PPJ59F–Ispirazione che mostra il segno Big Data. Parola per gli insiemi che così complesso che il software tradizionale non può occuparsi di loro

RFFAB8JA–Complesso di antenna di ricezione di dati di telemetria circa lo stato del sistema (unità, impianti), che è ottenuto in remoto

RF2BN7YWP–Rete a forma di cervello. Big data rete neurale. Concetto di intelligenza artificiale. rendering 3d

RFH8CMGM–Grande complesso di dati. Grafica di sfondo astratto di comunicazione. Sfondo in prospettiva di profondità. Array minimo con composti di linee e di punti. Digital per la visualizzazione di dati. Illustrazione vettoriale di dati di grandi dimensioni.

RF3CN46KN–Assistente clienti chatbot AI che fornisce soluzioni rapide per i problemi di fatturazione e ordine, elaborando dati complessi in background per fornire informazioni accurate e precise

RF2B7YTY8–Contesto vettoriale del sistema scientifico e tecnologico per il calcolo di dati complessi.

RF3D2D11N–Un'interfaccia utente futuristica per la business intelligence. Questo dashboard avanzato ai visualizza analisi di dati complessi, grafici e grafici per il cuore strategico

RF2PJXDD4–Scienza dei dati e tecnologia dei big data. Il data scientist calcola, analizza e visualizza set di dati complessi sul computer. Data mining, artificiale intell

RF2MB4JD5–Fogli di calcolo di dati complessi con frecce verdi che puntano verso l'alto per indicare un positivo slancio delle vendite e un utile

RF2J69GF2–Tecnologia digitale Hi-Tech, concetto di diagramma delle onde di frequenza, hud futuristico che visualizza dati complessi, monitor in prospettiva per le presentazioni

RFW0WX41–Vettore grande astratto per la visualizzazione di dati. Complesso thread di dati grafico. Abstract la grafica vettoriale. Infografico futuristico illustrazione.

RFM17FK5–Nodo, punti e linee. Particelle di astratta geometrica sfondo grafico. Struttura di atomi, molecole e comunicazione. Grande complesso di dati con composti.

RF2B6D6T9–Infografica futuristica. Informazioni design estetico. Visualizzazione grafica di thread di dati complessi. Grafico dati astratti

RMD1T05K–Un centro dati complesso in cui Amazon.com è noto di locazione dello spazio in ASHBURN, Virginia.

RF2XF5YY4–Un uomo d'affari in una tuta grigia interagisce con un'interfaccia digitale futuristica che visualizza dati, grafici e pianificazioni complessi. Questa immagine evidenzia la u

RF3B838BD–Health Data Privacy come argomento complesso, legato a importanti argomenti che si diffondono come Word cloud.

RF2PYFPEP–Didascalia di testo che presenta i big data. Parola per gli insiemi che così complesso che il software tradizionale non può occuparsi di loro

RM2PPMKHB–Testo che mostra l'ispirazione Big Data. Parola scritta sugli insiemi che così complesso che il software tradizionale non può occuparsi di loro

RF2B5JX8N–Linee Sottili Diagonali Circolari Incrociate (Curve Hatch Work) Texture Astratta. Cristo Monocromatico Croce Sfondo Geometrico. Quantum E Big Data Complex.

RFH8CMM9–Grande complesso di dati. Grafica di sfondo astratto di comunicazione. Sfondo in prospettiva di profondità. Array minimo con composti di linee e di punti. Digital per la visualizzazione di dati. Illustrazione vettoriale di dati di grandi dimensioni.

RF3D3113W–Un assistente di intelligenza artificiale generativa mostra le sue capacità di elaborazione dei dati. Questo sistema automatizza i flussi di lavoro delle informazioni e gestisce pipeline di dati complesse u

RF2X8ED3K–Sono visibili più schermate che visualizzano analisi di dati complessi e grafici finanziari

RF2MNPJM4–Tecnologia dei big data e scienza dei dati. Ricercatore di dati che interroga, analizza e visualizza set di dati complessi su schermo virtuale. Concetto di flusso di dati. Neurale

RF2MB4JDC–Foglio elettronico di dati complesso con frecce verdi e rosse e un punto interrogativo come simbolo di una prospettiva economica e commerciale molto incerta

RFT4369T–Hi-tech la tecnologia digitale di frequenza diagramma wave concept futuristico, hud la visualizzazione di dati complessi, concetto creativo per la presentazione per pr finanziarie

RFDPD925–Design piatto illustrazione moderno concetto di grande statistiche dati e complesso processo di analisi avanzate nel settore diversi

RFM17J24–Nodo, punti e linee. Particelle di astratta geometrica sfondo grafico. Struttura di atomi, molecole e comunicazione. Grande complesso di dati con composti.

RF2B2PPN1–Infografica futuristica. Informazioni design estetico. Visualizzazione grafica di thread di dati complessi. Grafico dati astratti

RMD1T053–Un centro dati complesso in cui Amazon.com è noto di locazione dello spazio in ASHBURN, Virginia.

RF2PYE8ER–Scrittura a mano di testo Big Data. Il concetto di business è talmente complesso che il software tradizionale non può affrontarlo

RM2PPJ3RD–Soluzione complessa per la scrittura a mano. Concetto che significa tempo di computer o servizio, inclusi i servizi di elaborazione dati Woman Holding Pen e Learning Skill tramite Virtual Reality Simulator.

RFMEK43X–Abstract poligonale bianco triangoli connessi, linee, punti dello sfondo. Le moderne tecnologie illustrazione vettoriale. Grafica geometrica grande complesso di dati

RFH8CMMK–Grande complesso di dati. Grafica di sfondo astratto di comunicazione. Sfondo in prospettiva con mappa del mondo. Array minimo con composti di linee e di punti. Digital per la visualizzazione di dati. Illustrazione vettoriale di dati di grandi dimensioni.

RF3D17471–L'INTELLIGENZA ARTIFICIALE alimenta una rete neurale per elaborare flussi di dati complessi, ottimizzare i modelli di apprendimento e automatizzare l'elaborazione intelligente ad alta velocità su reti Vo

RF2T4C7C1–Big data e tecnologia di intelligenza artificiale. Scienza dei dati e analisi dei dati. Scienziato che analizza insiemi di dati complessi su computer. Data mining, intelligenza artificiale, m

RF2W9HWFE–Dati estremamente complessi con numeri provenienti da un sistema di contabilità. Simbolico per un contesto economico instabile durante la crisi e la recessione.

RF2J6E9RT–Ordinamento e analisi di big data complessi, visualizzazione di reti di comunicazione, database di informazioni, illustrazione della tecnologia vettoriale

RF2FN4A57–Cyber-complessi di settore: Buona visulizzazione dei big data. Informazioni generali astratte sul flusso di big data.

RFT64B5Y–Complessa rete di nodi della struttura. Plexus connessione dati. I punti e le linee dello sfondo. Illustrazione Vettoriale

RF2B2PDK0–Infografica futuristica. Informazioni design estetico. Visualizzazione grafica di thread di dati complessi. Grafico dati astratti

RMD1T05X–Un centro dati complesso in cui Amazon.com è noto di locazione dello spazio in ASHBURN, Virginia.

RF2PYEHY0–Visualizzazione concettuale dei big data. Set di foto concettuali così complessi che il software tradizionale non può affrontare con loro

RF2C8KGGW–Molecola grafica geometrica di sfondo e comunicazione. I big data sono complessi con composti. Linee plesso. Rendering 3D
RF2WPRBM0–Ricerca di bug di stomaco, immagine concettuale. Scienziato pipettando un campione in una piastra di Petri con un modello molecolare di una particella di rotavirus nel backgroun

RF2Y7PDBN–Visualizzazione complessa di dati e tecnologie che lavorano insieme. Sfondo dell'illustrazione 3D.

RFH8CMH3–Grande complesso di dati. Grafica di sfondo astratto di comunicazione. Sfondo in prospettiva con mappa del mondo. Array minimo con composti di linee e di punti. Digital per la visualizzazione di dati. Illustrazione vettoriale di dati di grandi dimensioni.

RF3D21964–L'INTELLIGENZA ARTIFICIALE alimenta una rete neurale per elaborare flussi di dati complessi, ottimizzare i modelli di apprendimento e automatizzare l'elaborazione intelligente ad alta velocità su reti Vo

RF2T2E639–Analisi dei dati e tecnologia ai. Scienza dei dati e big data. Scienziato che analizza insiemi di dati complessi su computer. Data mining, intelligenza artificiale, m

RF2W9HNFH–Dati estremamente complessi con numeri in dollari provenienti da un sistema di contabilità. Simbolico per un contesto economico instabile durante la crisi e la recessione.
























